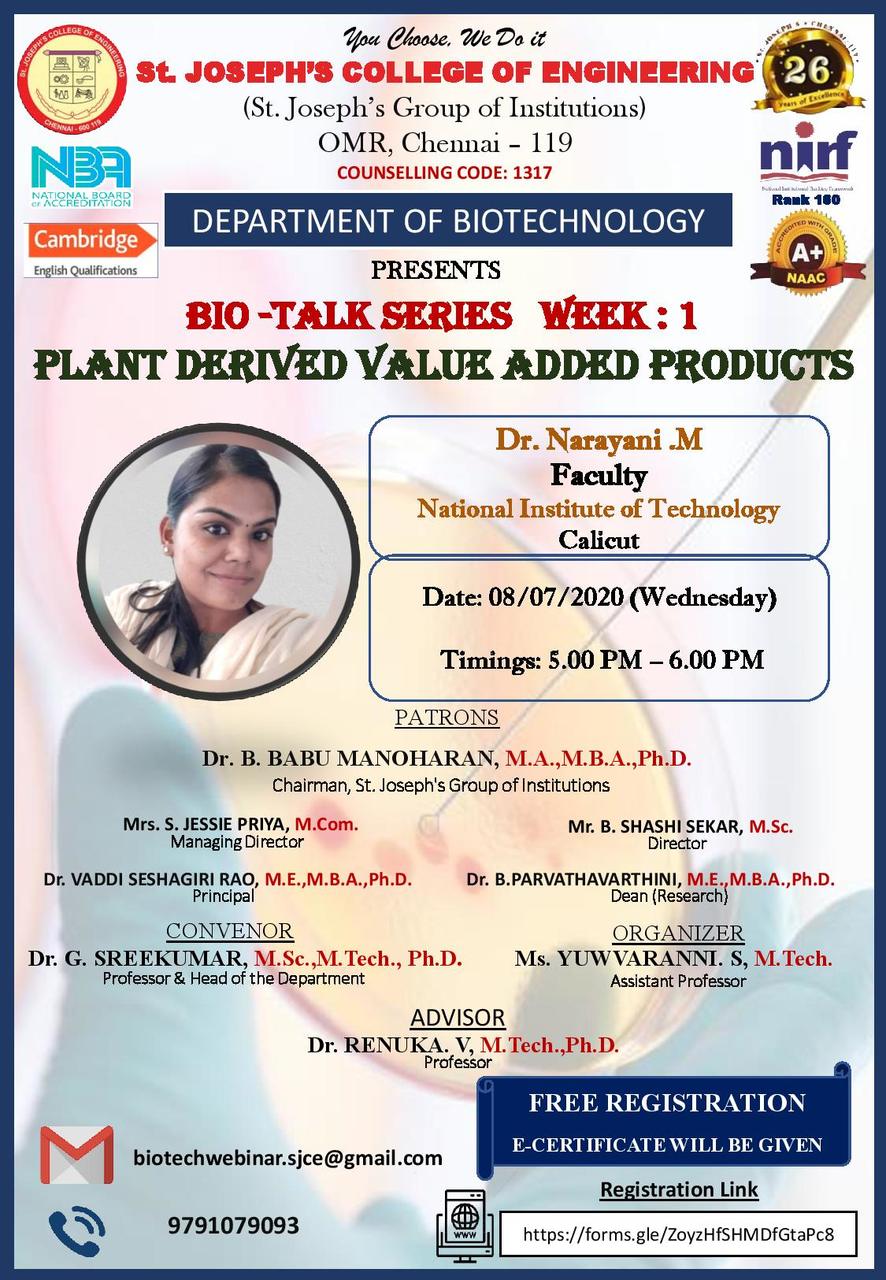

- Webinars and FDPs
- Club activities / Department Socitiy / Chapter activities / School students competitions

- Webinars and FDPs
- Club activities / Department Socitiy / Chapter activities / School students competitions




































- Webinars and FDPs
- Club activities / Department Socitiy / Chapter activities / School students competitions






























- Webinars and FDPs
- Club activities / Department Socitiy / Chapter activities / School students competitions












































- Webinars and FDPs
- Club activities / Department Socitiy / Chapter activities / School students competitions























































































































- Webinars and FDPs
- Club activities / Department Socitiy / Chapter activities / School students competitions



















































- Webinars and FDPs
- Club activities / Department Socitiy / Chapter activities / School students competitions

















- Webinars and FDPs
- Club activities / Department Socitiy / Chapter activities / School students competitions










































- Webinars and FDPs
- Club activities / Department Socitiy / Chapter activities / School students competitions






























































































































































































